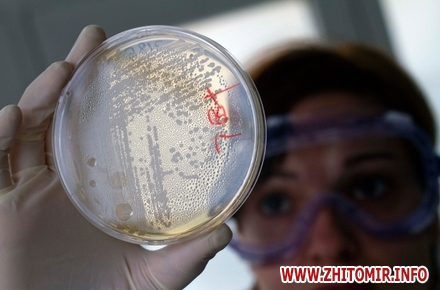

Нові випадки підтвердженого лікарями діагнозу «ротавірусна інфекція» зареєстровані у навчально-виховному комплексі №38 м. Житомира.
Про це Житомир.info 25 січня розповіла мама учениці цього закладу.
«Двоє дітей з одного класу початкової школи захворіли на цю інфекцію, плюс ще мама однієї з них. Діагноз «ротавірусна інфекція» жінці підтвердили в поліклініці. Одну дитину забрала «швидка». Батьки перелякані, щоб не було масового захворювання, як у 23-й школі», - каже читачка.
Заступник міського голови Житомира Матвій Хренов заспокоює: на ротавірусну інфекцію щодня хворіють люди, в тому числі школярі, і про черговий спалах говорити рано.
«Щодня у лікарні потрапляє одна-дві дитини з діагнозом «ротавірусна інфекція». Так було і так буде. Це інфекція типу грипу, яка є постійно. Особливістю ситуації, яка склалася у 23-й гімназії, було одномоментне занедужання великої кількості дітей. Якщо ви подзвоните через 2 тижні, то буде ще 2-3 дитини, які лікуються з таким діагнозом. Про спалах можна говорити, якщо є 5 дітей, що захворіли. Але я підкреслюю, і це можна перевірити з відкритих джерел. Завжди в інфекційному відділенні міської дитячої лікарні є 20 школярів, половина яких лікується з діагнозом «ротавірусна інфекція», - прокоментував Матвій Хренов.
Як повідомляв Житомир.info, 24 січня Матвій Хренов назвав причину масового захворювання учнів Житомирської міської гуманітарної гімназії №23: ротавірусна інфекція. Нагадаємо, 21 січня 13 учнів різних класів гімназії були госпіталізовані з ознаками харчового отруєння. З понеділка, 30 січня, навчання у гімназії відновлюється.
























